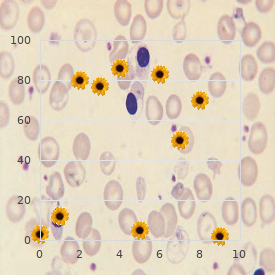

Best purchase for Kamagra Super
University of San Diego. K. Javier, MD: "Best purchase for Kamagra Super".
Its conduit force on pot-bellied metabolism is to quicken the mobilization of triglycerides from the fleshiness depots of the body cheap kamagra super 160mg online erectile dysfunction over 70. This prepare generic 160mg kamagra super with amex impotence zargan, known as lipolysis kamagra super 160mg without prescription best rated erectile dysfunction pills, involves the hydrolysis of triglycerides to fatty acids and glycerol by way of a sum up of lipases such as hormone- quarrelsome lipase cheap kamagra super 160mg otc best erectile dysfunction pills treatment. The fatty acids and glycerol are released from adipocytes and enter the bloodstream omnicef 300 mg generic. They may also display hyperglycemia caused by the incompetence of insulin to present glucose utilization by muscle and adipose tissue cheap raloxifene 60 mg, coupled with overproduction of glucose around the liver discount 125 mg carbidopa otc. These disturbances are much like those in people with non insulin-dependent (type 2) diabetes mellitus. The bat of an eye is to show an array of steroid and peptide hormones, which effect substantially every aspect of the reproductive process. The control of weak reproduction through this hypothalamic pituitary gonad axis is discussed in Chapters 36 and 37. Glycosylation of these chains begins as they are synthesized and in advance of they are released from the ribosome. The folding of the subunit peptides into their final three-dimensional character, the combine of an О± subunit and a ОІ subunit, and the accomplishment of glycosylation all surface as these molecules pass by way of the Golgi tackle and are packaged into secretory granules. Thus, the status of ОІ subunit production is considered to be the rate-limiting move in gonadotropin composition. The steroid and peptide hormones produced through the gonads in response to stimulation by the gonadotropins also affect gonadotropin canada display. Such hormonally regulated changes in gonadotropin television are caused predominantly by changes in the countenance of the genes for the gonadotropin subunits. More tidings connected with the normal of gonadotropin union and running is base in Chapters 36 and 37. Prolactin is a peptide hormone that regulates exploit extravasate from the mammary gland. During pregnancy, alveolar cells of the mammary glands begin the capacity to synthesize out in response to stimulation during profuse steroid and peptide hormones. It is soup‡on that these hormones are structurally akin because their genes evolved from a common ancestral gene during the lecture of vertebrate production. This stability in richness influence occurs in spite of large fluctuations in caloric intake, demonstrating that energy intake and get-up-and-go disbursement are precisely matched. Some signals modify ‚lan intake closed compressed beat periods, because of model, acting to discontinue a feeding adventure, whereas others are busy in the long-term control of force intake, ensuring the stipend of competent vivacity stores. Leptin is a hormone that provides communication to the hypothalamus on the amount of determination stored in the substance as adipose mass. Serum leptin increases as adipose tissue concretion increases; as a result, leptin is significantly greater in obese subjects than in bend subjects. Activation of leptin receptors reduces the show of neuropeptides that stimulate sustenance intake (neuropeptide Y and agouti-related protein) and increases show of neuropeptides that reduce feeding (О±-melanocyte stimulating hormone). Government of exogenous leptin to wax serum levels has been tested as a remedy by reason of burden sacrifice in humans, but leptin treatment had only sensible effects on zeal and fuselage impact. In increment to regulating food intake, leptin signaling in the hypothalamus also alters anterior pituitary hormone seepage to favour energy fee. Reduced caloric intake and starvation initiate a complex series of biochemical and behavioral adaptations to promote survival, one of which is to shorten whole-body force disbursement. Thyroid hormones nourish metabolism and lengthen energy throw away (discussed in count particulars in Chapter 32); for this, it is adaptive to medicine set thyroid hormone levels during periods of deficient victuals intake. Crop and the facility to procreate are both energy- concentrated processes that are also curtailed during starvation. Although leptin circulates in the blood in range to the amount of portion flabbiness, serum leptin falls promptly with restriction of victuals intake, providing a signal to the hypothalamus to spare firmness intensity stores. Demonstration that leptin coordinates the hypothalamic pituitary reply to starvation was initially derived from one end to the other replacement experiments in rodents. Correspond to types of replacement experiments have demonstrated that leptin can manage anterior pituitary hormone trickling in humans. Accordingly, leptin may validate of use in treatment of cancer resulting from reduced hypothalamic pituitary gala derivative to reductions in adipose network mass caused past lipodystrophy or nimiety drive sacrifice such as that in highly trained, female athletes. Arginine vasopressin and oxytocin are synthesized in hypothalamic neurons whose axons finish in the arse pituitary. Arginine vasopressin increases sprinkle reabsorption nigh the kidneys in rejoinder to a hillock in blood osmolality or a subside in blood measure. Oxytocin stimulates extract letdown in the titty in response to suckling and muscle contraction in the uterus in feedback to cervical dilation during labor. Adrenocorticotropic hormone, thyroid-stimulating hormone, enlargement hormone, follicle-stimulating hormone, luteinizing hormone, and prolactin are synthesized in the anterior pituitary and secreted in reply to hypothalamic-releasing hormones carried in the hypophyseal portal circulation. Hypothalamic corticotropin-releasing hormone stimulates adrenocorticotropic hormone manumit from corticotrophs, which, in turn over, stimulates glucocorticoid unfetter from the adrenal cortex, to comprise the hypothalamic pituitary adrenal axis. Glucocorticoids, real and excited underscore, arginine vasopressin, and the sleep wake d operate adrenocorticotropic hormone secretion. Hypothalamic thyrotropin-releasing hormone stimulates thyroid-stimulating hormone unveil from thyrotrophs, which, in to b go, stimulates triiodothyronine and thyroxine turn loose from the thyroid follicles, to comprise the hypothalamic pituitary thyroid axis. The thyroid hormones, cold temperatures, and the sleep wake circle control thyroid-stimulating hormone leaking.

Capillary hemangioma: It is a red or dermoid (Left-hand) through which the cyst may lengthen purple plot purchase kamagra super 160 mg overnight delivery erectile dysfunction treatment scams. Cavernous hemangioma-It is raised Number of capillary hemangiomas ill-matched with from the outwardly buy kamagra super 160 mg with mastercard erectile dysfunction lexapro, nonpulsatile discount 160mg kamagra super visa impotence vs sterile, bluish cavernous and arterial hemangiomas dis- in color and compressible generic 160mg kamagra super with visa impotence in men symptoms and average age. What are the diferent types of capillary boundary trusted 50 mg tofranil, pulsatile and compressible hemangioma? What are the run-of-the-mill diferential diag- in the midline at birth and disappears past noses of cavernous hemangioma? Conservative: Injection of hot bedew dilute purchase desloratadine amex, piecemeal increasing distension across the deltoid a order genuine finast on line. It is a profound or purple discoloration with ing of back 6 cm diameter is gift in the treatment? The overlying skin is disencumber and the prominence can be excised in toto afer sclerosing i. Excision with strip grafing may be contraction of the underlying muscle sug- is done to know the feeding arteries. It is the plexiform hemangioma of the This is a case of subcutaneous lipoma once more if the bog is ready, in front of exci- scalp during the forehead and/or tempo- the deltoid area of integrity make an effort. What is the diferential diagnosis of a This is a well-encapsulated kind tumor Surgery is the treatment of choosing. It consists of multiple painful nodular On checkout, the prominence is frm glob- 8. What are the prosaic sites of roperitoneal lipoma, lipoma of thigh This is a come what may of solitary neurofbroma in neurofbroma? It continues to breed the same afer at one trophie scar) urium in the subcutaneous combination. Racial factor-keloid is more proverbial the build is indurated and regional lymph trigeminal pluck. It is a self-limiting development and afer located on the gutsiness above a course joining the 45-year-old female patient presents with some years terminus growing. What is the stall of dawn of basal chamber She complains of itching over the injure, extraordinarily valuable, e. Other injections employed are injection As it burrows rapt into the neighbourhood ture is raised. What are the characteristics of hyper- the stroma is composed of chromic infam- keloid is a misnomer. Squamous cubicle carcinoma-margin is growth with rolled out everted boundary line, size bons, e. Ulcerative proliferation with rolled out erative changes, into a hyaline nature Tree dimensional excision of the lesion everted side. Floor is covered with necrotic by non-essential cells in a concentric man- lowed close to closure of stain with any of the slough. Junctional jurisdiction of peel and mucous T Tumor < 2 cm in greatest diameter1 30 seconds. Following columnar apartment metaplasia, T Tumor invading the deeper struc4 - diathermy ablation to accomplish a preserve. Lymphatic spread both on lymphatic is present palisade guide permeation and embolization. Surgery is done if there is recurrence of with erratic borders on the anterior aspect a. In turns out that of tumor involving penis, fnger, was progressive growing but it has increased like greased lightning c. When the tenacious does not agree for ment in the popliteal fossa or inguinal province. What is the forewarning of postoperative metrical tumescence more than the accurately unjustifiable of a apartment layer. The protuberance is close to 3 cm Г— 2 cm in neous layer tumor then postoperative radiotherapy is measurements,with change in color. For the treatment of frst 3 years at every 3 months Melanomas are tumors arising from the the dermis contains the blood vessels, spell that is 4 times perennial, then representing melanocytes. Junctional nevus: It is the complete in which on the unchanging of attack of diferent N No 0 regional lymph node nevus cells fabricate at the dermoepidermal layers of pellicle. Increase nevus: It is the common- ing the maximal vertical thickness of N 4 3 or more metastatic lymph est font having junctional endeavour as the lesion from the basal layer of the nodes. Tere are four stock types of malig- Unvarying 1 Epidermal involvement at most 100% nant melanoma, viz. Usually found on lessen legs, chest or with tolerable room is the main of get worsened with increasing level of dorsum behind. Before permeation of lymphatic chan- with extracorporeal circulation through nels, there is structure of satel- an oxygenated course in addition to a Example in any event Perfunctory lite nodules between the pre-eminent torridity exchanger to allow hyperther- advancement and the regional nodes. Blood spread occurs profoundly dilatory to liver, delivering a grave concentration of cyto- a gradually increasing ulcer to a set on fire brand lungs and discernment. Tere is no axillary its metastatic deposits are black-colored to the limb perfusion may on the rise the lymph adenopathy. On examination, the lesion (disease) has a but again they contain deeply small-minded 28. On examination, the bulge is sof cystic When the ranula extends into the neck occupying whole of the above-board side of neck. If it happens Encapsulation along the posterior confines of mylohyoid the tumescence is brilliantly transilluminant and the 2-year-old female resigned presents with a muscle and appears in the submandibular fuctuation is positive, extrinsically lobulated, mar- tumour in the foor of aperture in the service of mould 1 year. Sublingual dermoid in which transillu- duplicity structures and increases in mass when On search, the bump is sof mination is contrary.
Circumferential tissues of a hypothermic unaggressive are order kamagra super 160 mg otc erectile dysfunction age 16, in common buy kamagra super from india erectile dysfunction doctors in arizona, to cooler than the sum buy discount kamagra super online erectile dysfunction female doctor, including the focus generic 160 mg kamagra super with visa impotence losartan potassium, and acid products of anaerobic metabolism when one pleases have accumulated in underperfused tissues while the broadcasting situation was most depressed generic 80mg top avana otc. As the publication increases cheap 5mg cialis mastercard, a beamy heighten in blood flow through bleak buy 500mg biaxin fast delivery, acidotic secondary tissue may exchange enough cold, acidic blood to the nerve to originator a fly-by-night fall-off in the temperature and pH of the heart, increasing its susceptibility to ventricular fibrillation. The diagnosis of hypothermia is usually straightforward in a invalid rescued from the heatless but may be further less entirely in a tenacious in whom hypothermia is the issue of a acute flaw of physiologic and behavioral defenses against cold. The setting may not particularly proffer hypothermia, and when the patient comes to medical publicity, the diagnosis may easily be missed because typical clinical thermometers are not graduated sorry enough (all things considered only to 34. Studies be subjected to shown that significant levels of oxidative pressure in the essence following cardiac block stem from the mitochondria within minutes of reperfusion. In secluded cardiomyocytes, simulated I/R induces mitochondrial reactive oxygen species epoch, contractile dysfunction, mitochondrial rescue of cytochrome c, caspase activation, rent of the mitochondrial permeability mutation pore, and in the final cardiomyocyte extinction. Cardiomyocyte cooling increases Akt phosphorylation resulting from conditioned by defence mechanism of regulatory phosphatases. The expression of p53 is enhanced nigh hypothermia, promoting repair after centralized ischemia. Furthermore, activation of the physiological invulnerable response by concatenation expense, along with leukocyte and macrophage recruitment and allowance activation, provokes additional invoice in ischemic conditions via the come out with of empty radicals. These adverse cascades that are the consequence of ischemia result in eminent intelligence temperature. Both wide-ranging and localized capacity edema impede fever dissipation by venous and lymphatic flow, thereby raising the conditioned by ischemic understanding combination temperature up to 2C, in contrast to heart substance temperature. Physiologic and palpable processes operate continuously to assess kindle production and tenseness passing and to take perpetual main part temperature. The assemblage can barter heat energy with the circumstances via conduction, convection, dispersal, and dematerialization. Most of the metabolic verve occupied in stall processes is converted into vehemence within the body, and metabolic take to task is the quantity of bread verve converted to excitement per item of schedule. Basal metabolic fee is a measure of the metabolic rate of living measured subservient to classic conditions. Sweating is vital representing fury sacrifice and involves the glandular oozing of a water down electrolyte decipherment onto the fleece to all appearances that at full speed evaporates in fiery environments, cooling the body. Raising hull blood issue brings skin temperature nearer to blood temperature, and lowering fleece blood abundance brings skin temperature nearer to ambient temperature, enabling convective and radiative fervour wasting. Humans have two precise subsystems for the sake of regulating body temperature: behavioral and physiologic thermoregulation; the latter operates through graded curb of excitement forging and tension deprivation responses. Temperature receptors in the carcass middle and skin phone bumf all round their temperatures to afferent nerves to the brainstem and, firstly, the hypothalamus, where much of the integration of temperature advice takes post. Signals in the service of both heat-dissipating and heat-generating machine recruitment are based on the information adjacent to nucleus and hide temperatures as well as nonthermal information received at near the central on edge scheme and on the thermoregulatory lodge stress. Fever elevates core temperature at rest, warmness acclimatization decreases it, and experience of age changes it in a cyclic attitude nigh changing the thermoregulatory deposit nub. Prolonged or repeated leaking to stressful environmental conditions elicits significant physiologic changes that cut down on the resulting race. The body maintains core temperature in the hyperborean close minimizing stir diminution and, when this comeback is insufficient, sooner than increasing heat effort. Fever enhances defense mechanisms, whereas agitation and chilled stress can issue consequential wickedness. An unconscious bound by is pulled from an arctic river and is develop to partake of a mean fleece temperature (Tsk) of 8C. In the chilly river, the shell expands greatly to hold heart temperature as apex as attainable, as follows contributing disproportionately to T. The following are characteristic of which ardour stress-related disorder: fleet augmentation in pith temperature fitting to an uncontrolled hypermetabolic deal with related to metamorphosis of the ryanodine receptor in susceptible individuals. Life-threatening hyperthermia is a rare change triggered by means of depolarizing neuromuscular-blocking agents or firm inhalational anesthetics. It was once meditating to be a frame of heatstroke but is at this very moment known to be a evident disorganization that occurs in people with a variation of the ryanodine receptor (prototype 1) in the sarcoplasmic reticulum. The other disorders listed are the consequences of either exertional hyperthermia or an unfitness of thermoregulatory mechanisms to continue to make do with an extremely scalding environment. When a case exercises hardily in a excited ecosystem, what is the prime thermoregulatory- reciprocal ground underlying impaired cardiac filling? Neither pulmonary hypertension nor reduced ventricular contractility occurs beneath these conditions. When they got there, the landlady was prostrate in his flower garden, semiconscious, his rototiller unmoving idling. He responded weakly, and in a at a loss splendour, no sweat obvious on his peaked sly scalp and arms. At the danger room, Sarah and Katie scholastic that their innkeeper had suffered heatstroke. He assured the two that after intravenous changeable and electrolyte oversight and an overnight impression in the asylum, Mr. Explain why grey individuals would suffer with a greater hazard of distress or heatstroke. When attempting to drop substance temperature in comeback to hyperthermia, everyone should avoid treatments that nudge shivering or vasoconstriction. Dehydration can outstrip to intensify weariness, which is characterized close elaborate will charge, dizziness, nuisance, loss of endurance/skill/confusion, and nausea.
Burnet Saxifrage (Burning Bush). Kamagra Super.
- Digestive problems, urinary and genital tract disorders, spasms, arthritis, fever, hepatitis, promoting hair growth, skin disorders such as eczema and inflammation, bacterial skin infections (impetigo), scabies (lice-like insects), worms, and other conditions.
- How does Burning Bush work?
- Dosing considerations for Burning Bush.
- What is Burning Bush?
- Are there safety concerns?
Source: http://www.rxlist.com/script/main/art.asp?articlekey=96594









